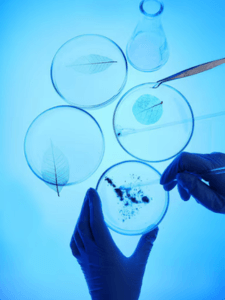
research-lab

Envision Easier NTA
The Envision NTA instruments were designed from the outset for superior usability, reliability and sample throughput. Sample introduction is simple and consistent with pipette loading, avoiding problems with syringe connections. The built-in sample pump ensures consistent, bubble-free sample loading, repeatable flow speeds, and easy cleaning cycles through a fully automated SOP. The sealed sample cell is proven bubble-free and easily replaceable when needed for maximum up-time. Software built around user workflow and automating the user dependent variables through the use of advanced technology means sample operation is a breeze, thus removing operator variables and improving throughput and repeatability even further
Powering the Next Era of Nanoparticle Research
Envision provides the accuracy, flexibility, and speed researchers require to advance scientific discovery. Its design is focused on transforming complex particle analysis into clear, actionable results.

Precision Without Compromise
Advanced optical engineering ensures the accuracy and repeatability of particle measurements, making them suitable for publication-quality research.
Speed That Drives Discovery
Optimized workflows and fast data acquisition enable quicker transitions from sample to insight.
Engineered for Scientific Advancement
From an optimized optical system to refined engineering, the Envision platform enables a new level of performance and confidence in data.
Applications of our
Technology
Our advanced nanoparticle tracking solutions serve a wide range of research and industrial applications. From supporting advanced studies in leading laboratories to enabling specialized analyses of nano particles, our technology provides the precision and insights essential for driving innovation.

Water Recycling and Reuse
Increasing pressure on global water resources has accelerated the adoption of water recycling and reuse systems for municipal and industrial…

Lipid Nanoparticle Analysis
Lipid nanoparticles (LNPs) are essential for the development of nucleic acid therapeutics, gene therapies, and advanced drug delivery systems. The…

Exosome Characterization
What Are Exosomes? Exosomes are a critical focus area in modern biomedical research, particularly in fields such as drug delivery,…
Corelative Studies
Nanoparticle research increasingly uses correlative approaches because no single technique captures all particle properties. Combining complementary methods supports formulation optimization,…
What Makes Envision Best
Envision excels in precision, versatility, and ease of use for nanoparticle tracking and characterization. Built for rigorous research environments, it provides high-quality data, seamless integration with other techniques, and reliable results essential for scientific breakthroughs.

UNPARALLELED
SENSITIVITY
Lowest detection limit for greatest measurement range
ACCURATE CONCENTRATIONS
Well defined measurement volume and robust tracking
REPEATABLE AND REPRODUCIBLE
Stable optics and optimized statistics for trustworthy reproducibility
FLUORESCENCE THAT WORKS
Sensitive measurement for full efficiency without photo-bleaching
Get in touch with us
We’re here to answer your questions & explore new posibilities together.